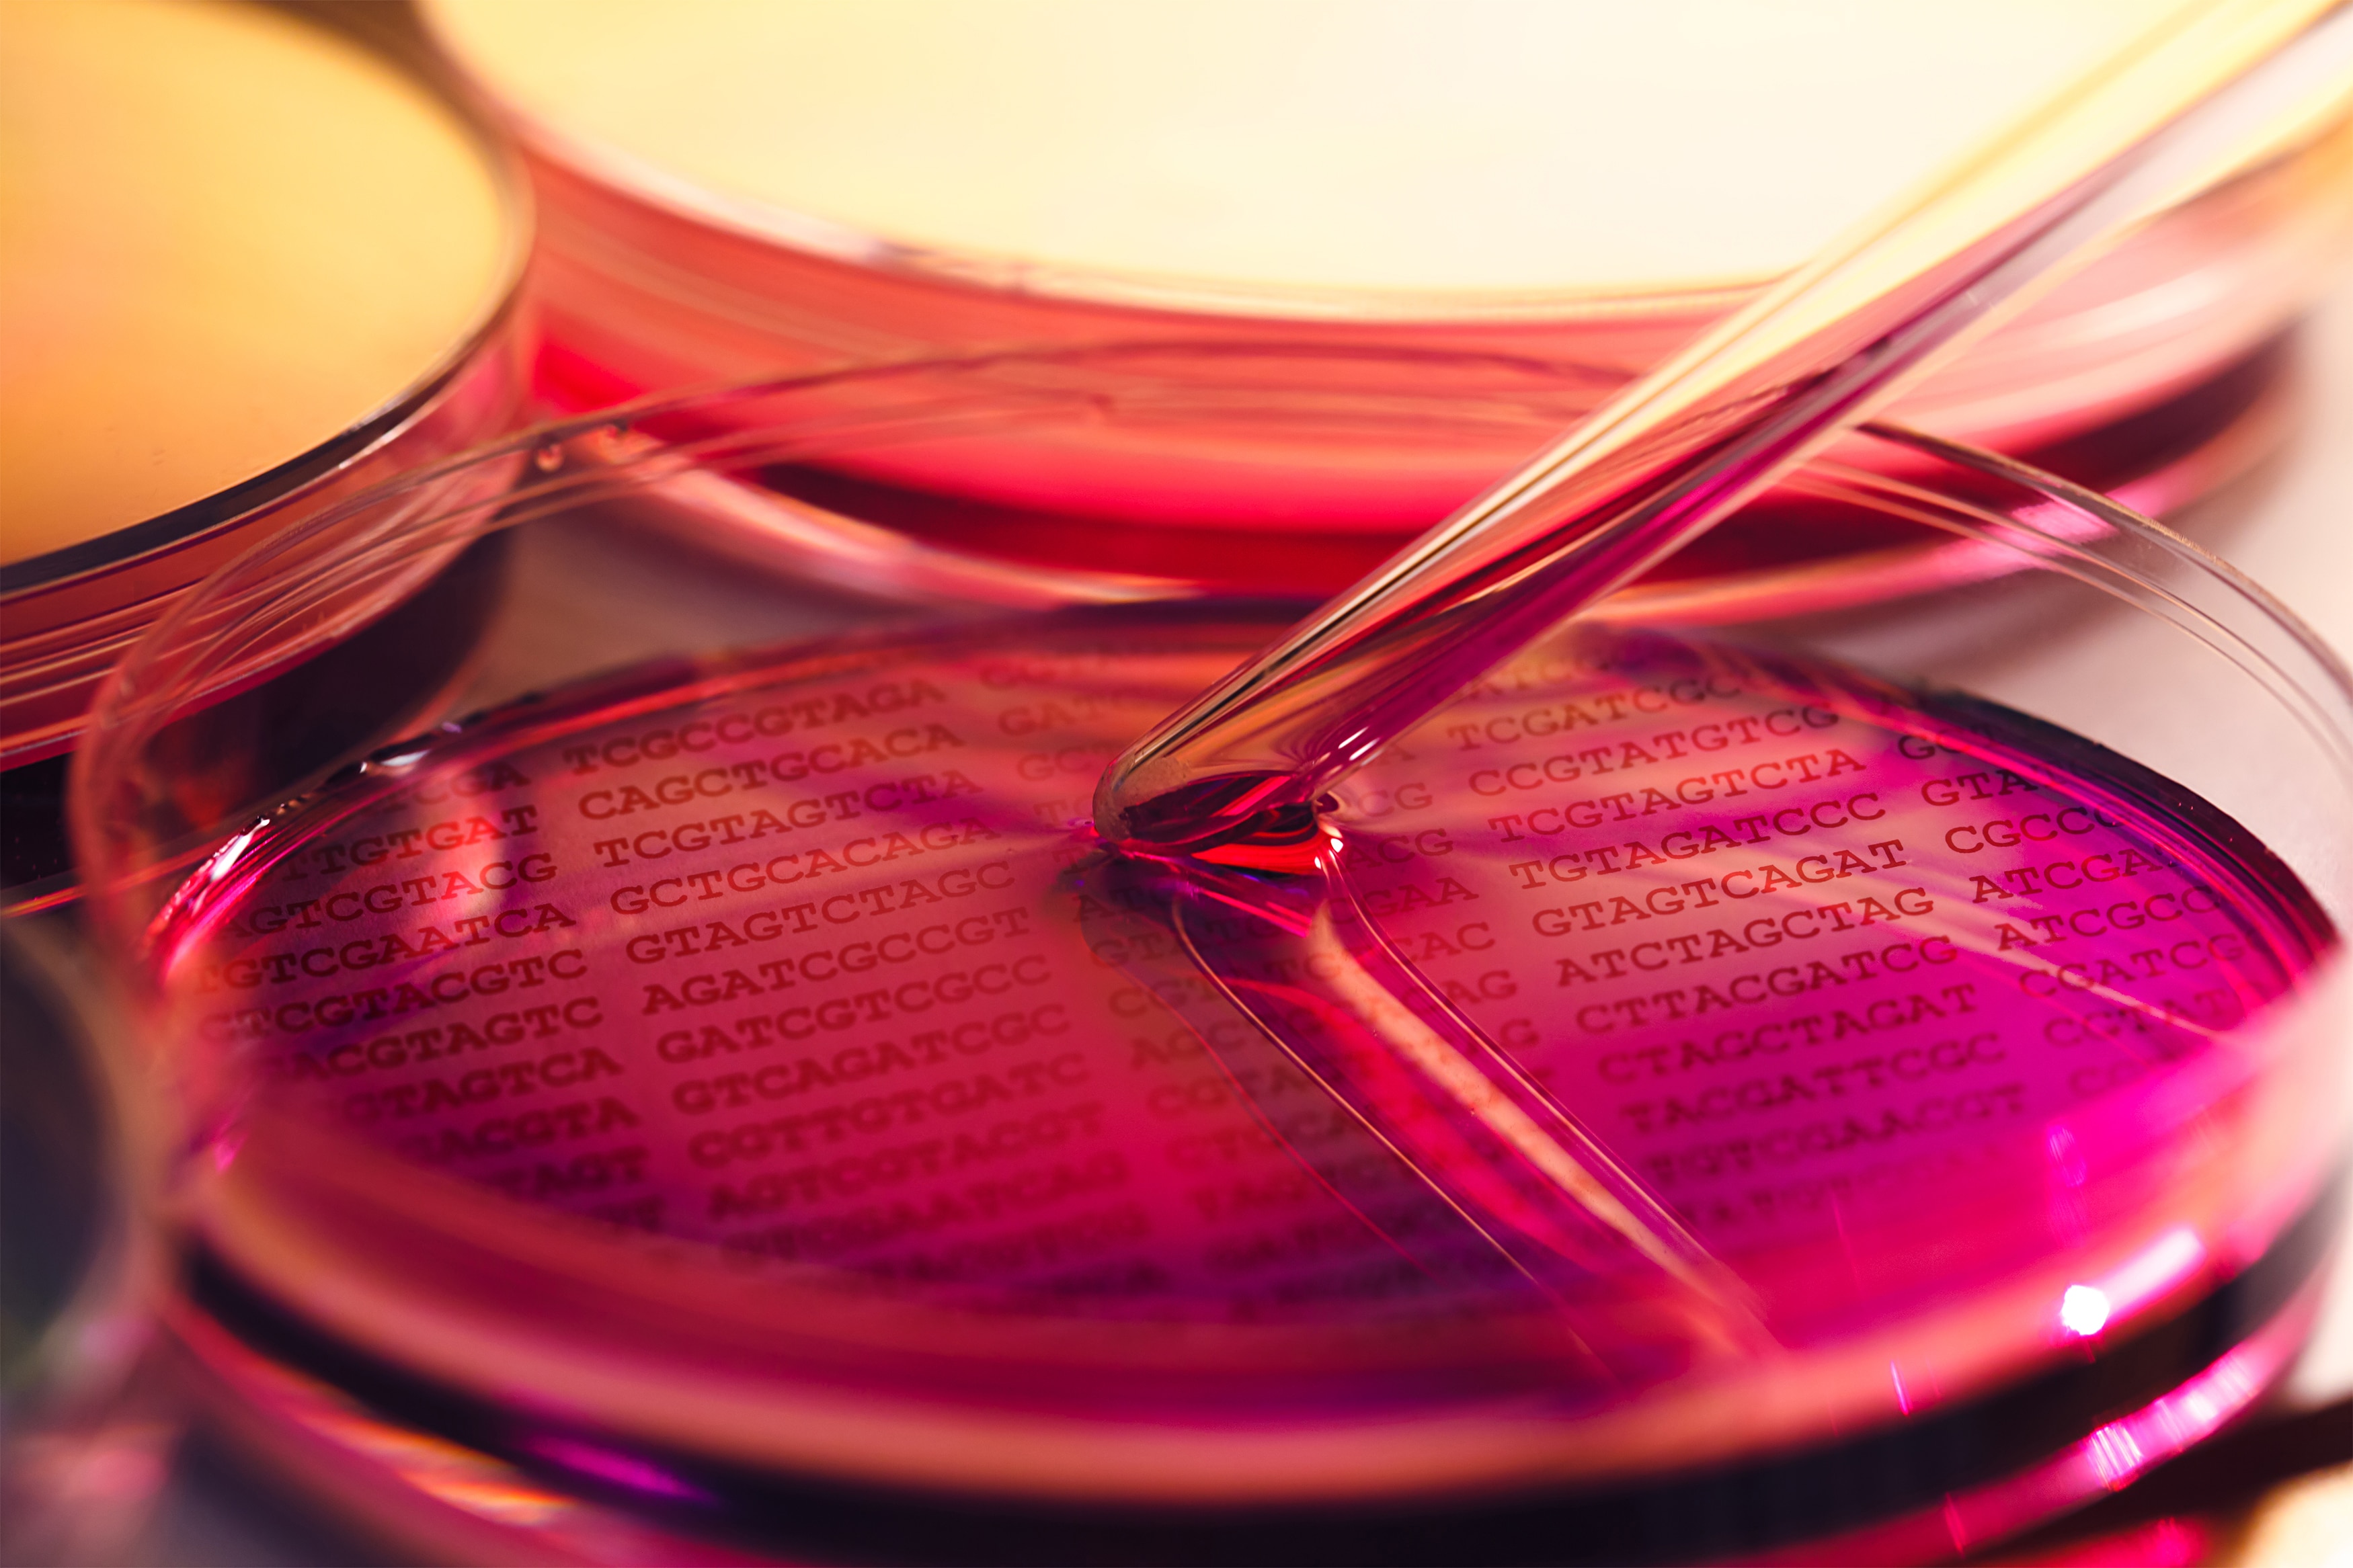

タンパク質低吸着・医療用コンパウンド
ゼラス™ CP / Zelas™ CP
詳しい資料はこちら
詳しい資料はこちら
ABOUT
ゼラス™ CPは、非晶性ポリオレフィンをベースにしたポリマーコンパウンド製品であり、高い透明性を有します。
医薬品の低吸着性、衛生性が求められる医療用バイアル、シリンジなどの医療機器の素材として好適な配合設計をしております。
ヒートシール性、異種材料接着性に優れており、2色成型や医薬用ソフトバックとして適用でき、医療機器部材のデザイン性の向上に寄与します。
※産業用途に関しては、 Tefabloc™ CP をご紹介しております。
FEAUTURE
1.高い透明性
紫外~可視光領域で高い透明性を有します。
380-600nmでの自家蛍光がなく、生化学分野での消耗品部材として好適です。
※UV領域で自家蛍光のない特殊グレードもありますので、詳細はお問合せください。

2.低分子量医薬/バイオ医薬 低吸着
抗体医薬(IgG)、血清タンパク(フィブリノーゲン)など、タンパク質薬剤への低吸着性を有するグレードを取り揃えております。

3.オレフィン材料との接着性
ポリプロピレン(PP)、ポリエチレン(PE)、環状ポリオレフィン樹脂(COP)、
スチレン系エラストマー(TPS)などに対して高い融着性を有します。
※オレフィン以外の樹脂や金属との接着性が必要な場合は、Tefabloc™ CPをご紹介しております。

4.低温接着性
エキシマーやコロナ処理などの前処理なしでの、低温(60℃)からの熱接着が可能です。
流路(寸法記載)2mmt (流路深さ 40μm)、蓋 2mmt
貼り合わせ条件:プレス温度(右表)、圧力 0.1MPa、時間 5min
<Evaluation Result>

〈結果〉
++:融着良好 + :融着不十分 - :流路一部潰れ
--:流路潰れ ーーー:融着せず
5.各国規制対応について
日本薬局方 7.02のプラスチック製医薬品容器試験法 溶出物/灰化試験
米国薬局方 USP ClassⅥ 対応グレードあり
6.レーザー溶着可能
レーザ溶着にも適応可能です。
レーザ溶着とは? (丸文株式会社ご提供)
項目 | 試験法 | 単位 | CP101 | CP207 | CP208 | CP209 |
特徴 | 高透明 | タンパク質薬剤低吸着性 | タンパク質薬剤低吸着性 | タンパク質薬剤低吸着性 | ||
用途例 | 射出一般 | シリンジ | バイアル/マイクロ流路 | シングルチャンバーバッグ | ||
MFR (230℃, 21N) | ISO 1133 参考 | g/10min | 7 | 5 | 1 | 4 |
曲げ弾性率 | ISO 178 参考 | MPa | 2000 | 1700 | 1600 | 1100 |
全光線透過率 | ISO 14782 参考 | % | 91 | 91 | 91 | 91 |
ヘイズ(2mmt) | ISO 14782 参考 | % | 1.5 | 3.0 | 1.5 | 7.0 |
Issued:Oct.2025
CASE

CONTACT
パフォーマンスポリマーズ製品の
お役立ち資料はこちらから
ご不明な点はお気軽に
お問い合わせください
Copyright © Mitsubishi Chemical Corporation, Performance Polymers Japan Department